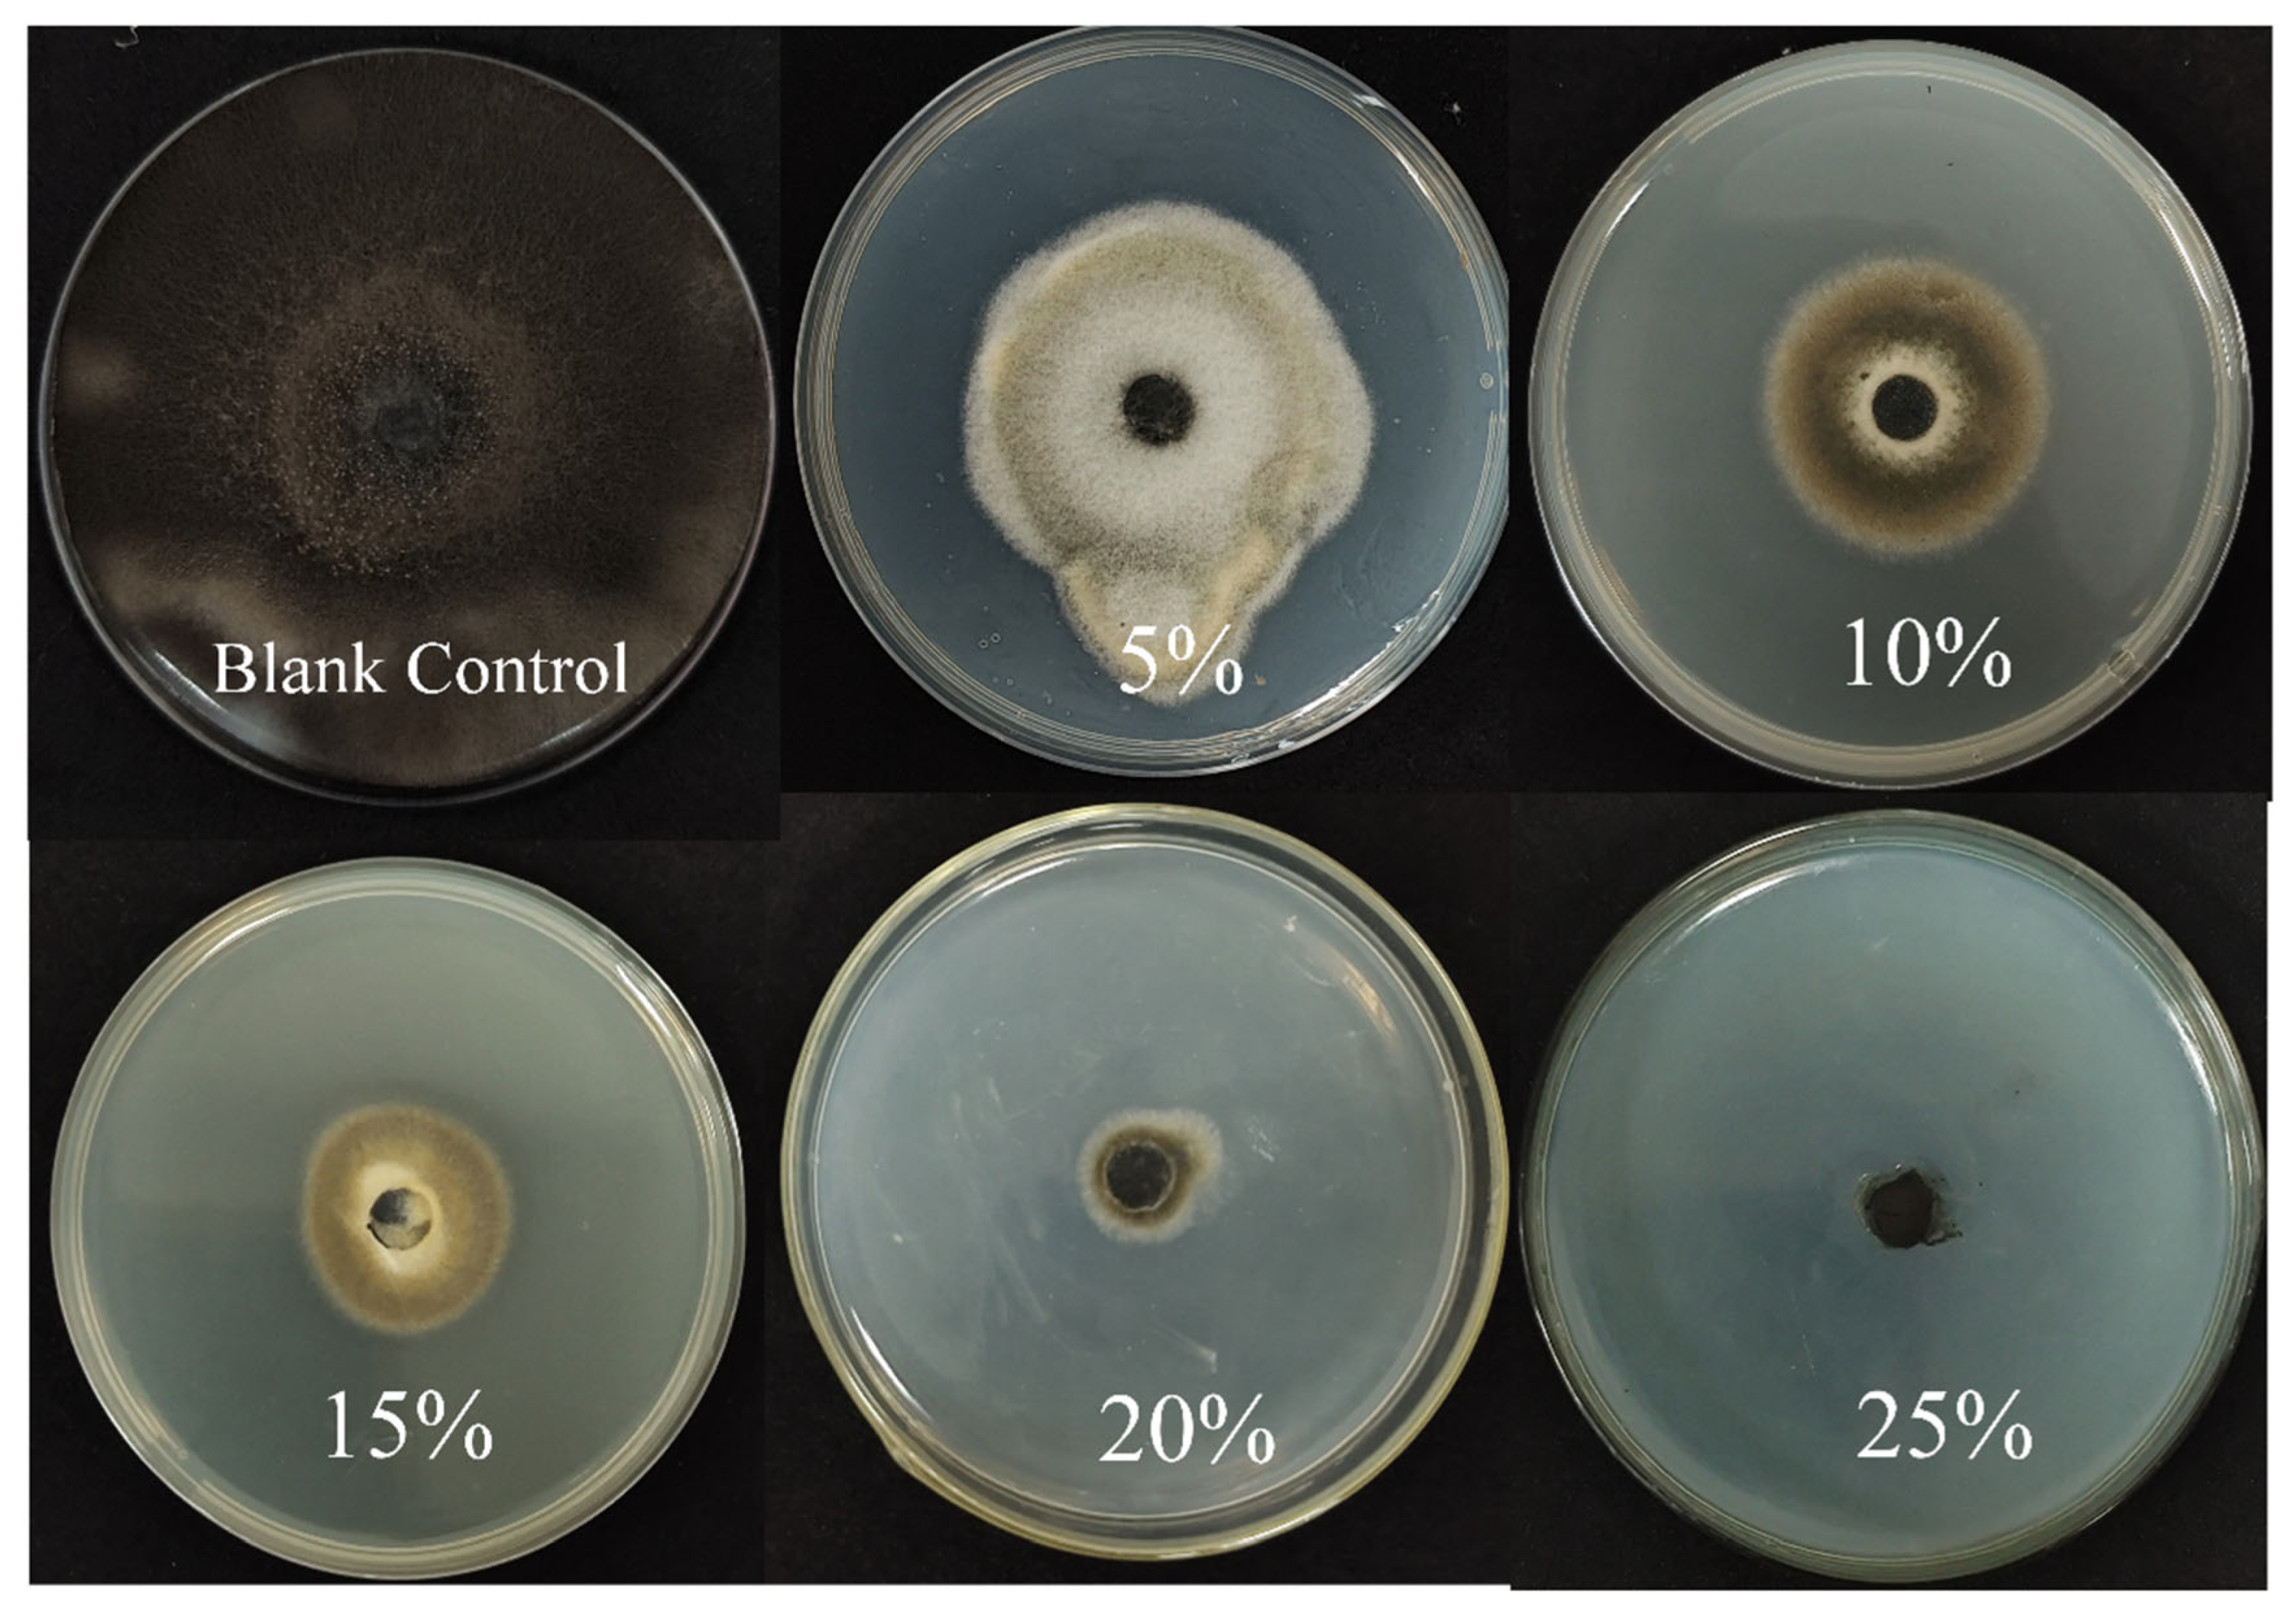
Jof 11 00446 g007

Isolation and Identification of Endophytic Bacterium B5 from Mentha haplocalyx Briq. and Its Biocontrol Mechanisms Against Alternaria alternata-Induced Tobacco Brown Spot
Abstract
1. Introduction
2. Materials and Methods
2.1. Endophytic Bacteria Were Isolated from M. haplocalyx
2.2. Screening of BCAs Antagonistic to Tobacco Brown Spot Disease In Vitro
2.3. Evaluation of the Antimicrobial Spectrum of Strains
2.4. Identification of the Antagonistic Strain B5
2.4.1. Morphological Identification
2.4.2. Biochemical and Physiological Indicators
2.4.3. Molecular Identification
2.5. Effect of B5 on Tobacco Red Star Disease Control in the Greenhouse
2.6. Determination of Biological Characteristics
2.6.1. Extracellular Enzyme Detection
2.6.2. Siderophore Production Assessment
2.6.3. IAA Synthesis Capability Test
2.6.4. Determination of the Ability to Form Biofilm
2.7. Study on Non-Volatile Compounds Produced by Strain B5
2.7.1. Impact of Bacterial Culture Filtrate on A. alternata Mycelial Growth
Detection of Antifungal Activity in Cell-Free Fermentation Broth
Observation of Hyphal Morphology by Scanning Electron Microscopy (SEM)
2.7.2. Extraction and Antifungal Activity Determination of Strain B5
2.7.3. LC-MS Analysis of Lipopeptide Active Substances of Strain B5
2.8. Identification of Enzyme Activity Related to Plant Defense
2.9. Statistical Analysis
3. Results and Analysis
3.1. Screening of Antagonistic Bacteria and Determination of Antifungal Spectrum
3.2. Antagonistic Bacteria B5 Identification
3.2.1. The Morphology of Colonies as Well as Their Physiological and Biochemical Traits
3.2.2. Phylogenetic Analysis
3.3. Control Effect of B5 on Tobacco Brown Spot Disease
3.4. Identification of the Biological Features of Strain B5
3.5. Effect of Sterile Filtrate (BCF) on Mycelial Growth of A. alternata
3.6. Determination of Antagonistic Activity of B5 Crude Extract
3.7. Identification of the Constituents in Strain B5 Extracts Using LC-MS
3.8. Impact of Strain B5 on Tobacco Defense-Related Enzyme Activity
4. Discussion
5. Conclusions
Supplementary Materials
Author Contributions
Funding
Institutional Review Board Statement
Informed Consent Statement
Data Availability Statement
Acknowledgments
Conflicts of Interest
References
- Xiang, L.G.; Wang, H.C.; Cai, L.T.; Guo, T.; Luo, F.; Hsiang, T.; Yu, Z.H. Variations in leaf phyllosphere microbial communities and development of tobacco brown spot before and after fungicide application. Front. Microbiol. 2022, 13, 1068158. [Google Scholar] [CrossRef] [PubMed]
- Tian, L.; Mei, G.; Long, Z.; Luo, D. Effects of Radix Curcuma fungicides on tobacco brown spot and yield of flue-cured tobacco leaves. Agric. Sci. Technol. 2016, 17, 1736. [Google Scholar]
- Hu, D.; Fan, Y.; Tan, Y.; Tian, Y.; Liu, N.; Wang, L.; Wu, A. Metabolic profiling on Alternaria toxins and components of Xinjiang jujubes incubated with pathogenic Alternaria alternata and Alternaria tenuissima via orbitrap high-resolution mass spectrometry. J. Agric. Food Chem. 2017, 65, 8466–8474. [Google Scholar] [CrossRef]
- Báez-Flores, M.E.; Troncoso-Rojas, R.; Osuna, M.A.I.; Domínguez, M.R.; Pryor, B.; Tiznado-Hernández, M.E. Differentially expressed cDNAs in Alternaria alternata treated with 2-propenyl isothiocyanate. Microbiol. Res. 2011, 166, 566–577. [Google Scholar] [CrossRef]
- Etesami, H.; Glick, B.R. Halotolerant plant growth–promoting bacteria: Prospects for alleviating salinity stress in plants. Environ. Exp. Bot. 2020, 178, 104124. [Google Scholar] [CrossRef]
- Llorens, E.; Fernández-Crespo, E.; Vicedo, B.; Lapeña, L.; García-Agustín, P. Enhancement of the citrus immune system provides effective resistance against Alternaria brown spot disease. J. Plant Physiol. 2013, 170, 146–154. [Google Scholar] [CrossRef]
- Chen, W.; Zhao, L.; Li, H.; Dong, Y.; Xu, H.; Guan, Y.; Rong, S.; Gao, X.; Chen, R.; Li, L.; et al. The isolation of the antagonistic strain Bacillus australimaris CQ07 and the exploration of the pathogenic inhibition mechanism of Magnaporthe oryzae. PLoS ONE 2019, 14, e0220410. [Google Scholar] [CrossRef]
- Eljounaidi, K.; Lee, S.K.; Bae, H. Bacterial endophytes as potential biocontrol agents of vascular wilt diseases–review and future prospects. Biol. Control 2016, 103, 62–68. [Google Scholar] [CrossRef]
- Kiesewalter, H.T.; Lozano-Andrade, C.N.; Wibowo, M.; Strube, M.L.; Maróti, G.; Snyder, D.; Jørgensen, T.S.; Larsen, T.O.; Cooper, V.S.; Weber, T.; et al. Genomic and chemical diversity of Bacillus subtilis secondary metabolites against plant pathogenic fungi. Msystems 2021, 6, 10–1128. [Google Scholar] [CrossRef]
- Naik, S.; Shaanker, R.U.; Ravikanth, G.; Dayanandan, S. How and why do endophytes produce plant secondary metabolites? Symbiosis 2019, 78, 193–201. [Google Scholar] [CrossRef]
- Bacon, C.W.; Whit, J.F. Physiological adaptations in the evolution of endophytism in the Clavicipitaceae. In Microbial Endophytes; CRC Press: Boca Raton, FL, USA, 2000; pp. 251–276. [Google Scholar]
- Venieraki, A.; Dimou, M.; Katinakis, P. Endophytic fungi residing in medicinal plants have the ability to produce the same or similar pharmacologically active secondary metabolites as their hosts. Hell. Plant Prot. J. 2017, 2, 51–56. [Google Scholar] [CrossRef]
- Sahu, P.K.; Singh, S.; Gupta, A.R.; Gupta, A.; Singh, U.B.; Manzar, N.; Bhowmik, A.; Singh, H.V.; Saxena, A.K. Endophytic bacilli from medicinal-aromatic perennial Holy basil (Ocimum tenuiflorum L.) modulate plant growth promotion and induced systemic resistance against Rhizoctonia solani in rice (Oryza sativa L.). Biol. Control 2020, 150, 104353. [Google Scholar] [CrossRef]
- Iantas, J.; Savi, D.C.; Schibelbein, R.D.; Noriler, S.A.; Assad, B.M.; Dilarri, G.; Ferreira, H.; Rohr, J.; Thorson, J.S.; Shaaban, K.A.; et al. Endophytes of Brazilian medicinal plants with activity against phytopathogens. Front. Microbiol. 2021, 12, 714750. [Google Scholar] [CrossRef] [PubMed]
- Saharkhiz, M.J.; Motamedi, M.; Zomorodian, K.; Pakshir, K.; Miri, R.; Hemyari, K. Chemical composition, antifungal and antibiofilm activities of the essential oil of Mentha piperita L. Int. Sch. Res. Not. 2012, 2012, 718645. [Google Scholar]
- Gul, P. Seasonal variation of oil and menthol content in Mentha arvensis Linn. Pak. J. For. 1994, 44, 16–20. [Google Scholar]
- AFarco, J.; Grundmann, O. Menthol-pharmacology of an important naturally medicinal “cool”. Mini Rev. Med. Chem. 2013, 13, 124–131. [Google Scholar] [CrossRef]
- Silva, F.C.D.; Chalfoun, S.M.; Siqueira, V.M.D.; Botelho, D.M.D.S.; Lima, N.; Batista, L.R. Evaluation of antifungal activity of essential oils against potentially mycotoxigenic Aspergillus flavus and Aspergillus parasiticus. Rev. Bras. De Farmacogn. 2012, 22, 1002–1010. [Google Scholar] [CrossRef]
- Khaledi, N.; Taheri, P.; Tarighi, S. Antifungal activity of various essential oils against Rhizoctonia solani and Macrophomina phaseolina as major bean pathogens. J. Appl. Microbiol. 2015, 118, 704–717. [Google Scholar] [CrossRef]
- Lopes, R.; Tsui, S.; Gonçalves, P.J.; de Queiroz, M.V. A look into a multifunctional toolbox: Endophytic Bacillus species provide broad and underexploited benefits for plants. World J. Microbiol. Biotechnol. 2018, 34, 94. [Google Scholar] [CrossRef]
- Alamri, S.A. Enhancing the efficiency of the bioagent Bacillus subtilis JF419701 against soil-borne phytopathogens by increasing the productivity of fungal cell wall degrading enzymes. Arch. Phytopathol. Plant Prot. 2015, 48, 159–170. [Google Scholar] [CrossRef]
- Jangir, M.; Pathak, R.; Sharma, S.; Sharma, S. Biocontrol mechanisms of Bacillus sp., isolated from tomato rhizosphere, against Fusarium oxysporum f. sp. lycopersici. Biol. Control 2018, 123, 60–70. [Google Scholar] [CrossRef]
- Xu, S.J.; Park, D.H.; Kim, J.Y.; Kim, B.S. Biological control of gray mold and growth promotion of tomato using Bacillus spp. isolated from soil. Trop. Plant Pathol. 2016, 41, 169–176. [Google Scholar] [CrossRef]
- Thines, M. Phylogeny and evolution of plant pathogenic oomycetes—A global overview. Eur. J. Plant Pathol. 2014, 138, 431–447. [Google Scholar] [CrossRef]
- Syed-Ab-Rahman, S.F.; Carvalhais, L.C.; Chua, E.; Xiao, Y.; Wass, T.J.; Schenk, P.M. Identification of soil bacterial isolates suppressing different Phytophthora spp. and promoting plant growth. Front. Plant Sci. 2018, 9, 1502. [Google Scholar] [CrossRef]
- Harwood, C.R.; Mouillon, J.M.; Pohl, S.; Arnau, J. Secondary metabolite production and the safety of industrially important members of the Bacillus subtilis group. FEMS Microbiol. Rev. 2018, 42, 721–738. [Google Scholar] [CrossRef]
- Zheng, T.W.; Liu, L.; Nie, Q.W.; Hsiang, T.; Sun, Z.X.; Zhou, Y. Isolation, identification, and biocontrol mechanisms of endophytic bacterium D61-A from Fraxinus hupehensis against Rhizoctonia solani. Biol. Control 2021, 158, 104621. [Google Scholar] [CrossRef]
- AN, I.; Grebenshchikova, A.V.; Yatsenko, E.S.; Speranskaya, N.Y.; Matsyura, A.V. Morphological diversity of Bacillus subtilis. Ukr. J. Ecol. 2018, 8, 365–370. [Google Scholar]
- Krieg, N.R.; Holt, J.G. Bergey’s Manual of Systematic Bacteriology; Yi Hsien Publishing Co.: Taipei, Taiwan, 1984. [Google Scholar]
- Patel, J.B. 16S rRNA gene sequencing for bacterial pathogen identification in the clinical laboratory. Mol. Diagn. 2001, 6, 313–321. [Google Scholar] [CrossRef]
- Ahmadi, Z.; Noormohammadi, Z.; Behzadi, P.; Ranjbar, R. Molecular detection of gyrA mutation in clinical strains of Klebsiella pneumoniae. Iran. J. Public Health 2022, 51, 2334. [Google Scholar] [CrossRef]
- Kumar, S.; Stecher, G.; Li, M.; Knyaz, C.; Tamura, K. MEGA X: Molecular evolutionary genetics analysis across computing platforms. Mol. Biol. Evol. 2018, 35, 1547–1549. [Google Scholar] [CrossRef]
- Fravel, D.R.; Spurr, H.W.; Harvey, J. Biocontrol of tobacco brown-spot disease by Bacillus cereus subsp. mycoides in a controlled environment. Phytopathology 1977, 67, 930–932. [Google Scholar] [CrossRef]
- Meng, X.J.; Wang, L.Q.; Ma, B.G.; Wei, X.H.; Zhou, Y.; Sun, Z.X.; Li, Y.Y. Screening, identification, and evaluation of an acidophilic strain of Bacillus velezensis B4-7 for the biocontrol of tobacco bacterial wilt. Front. Plant Sci. 2024, 15, 1360173. [Google Scholar] [CrossRef] [PubMed]
- GB/T 23222-2008; Grade and Investigation Method of Tobacco Diseases and Insect Pests. General Administration of Quality Supervision, Inspection and Quarantine of the People’s Republic of China, Standardization Ad-ministration of the People’s Republic of China: Beijing, China, 2008.
- Murthy, N.; Bleakley, B. Simplified method of preparing colloidal chitin used for screening of chitinase-producing microorganisms. Internet J Microbiol 2012, 10, e2bc3. [Google Scholar]
- Shin, S.H.; Lim, Y.; Lee, S.E.; Yang, N.W.; Rhee, J.H. CAS agar diffusion assay for the measurement of siderophores in biological fluids. J. Microbiol. Methods 2001, 44, 89–95. [Google Scholar] [CrossRef]
- Gang, S.; Sharma, S.; Saraf, M.; Buck, M.; Schumacher, J. Analysis of indole-3-acetic acid (IAA) production in Klebsiella by LC-MS/MS and the Salkowski method. Bio-Protocol 2019, 9, e3230. [Google Scholar] [CrossRef]
- Sun, D.; Zhuo, T.; Hu, X.; Fan, X.; Zou, H. Identification of a Pseudomonas putida as a biocontrol agent for tomato bacterial wilt disease. Biol. Control 2017, 114, 45–50. [Google Scholar] [CrossRef]
- Guardado-Valdivia, L.; Tovar-Pérez, E.; Chacón-López, A.; López-García, U.; Gutiérrez-Martínez, P.; Stoll, A.; Aguilera, S. Identification and characterization of a new Bacillus atrophaeus strain B5 as biocontrol agent of postharvest anthracnose disease in soursop (Annona muricata) and avocado (Persea americana). Microbiol. Res. 2018, 210, 26–32. [Google Scholar] [CrossRef]
- Wu, S.; Zhang, X.; Sun, Y.; Wu, Z.; Li, T.; Hu, Y.; Chen, B. Transformation and immobilization of chromium by arbuscular mycorrhizal fungi as revealed by SEM–EDS, TEM–EDS, and XAFS. Environ. Sci. Technol. 2015, 49, 14036–14047. [Google Scholar] [CrossRef]
- Mandal, S.M.; Sharma, S.; Pinnaka, A.K.; Kumari, A.; Korpole, S. Isolation and characterization of diverse antimicrobial lipopeptides produced by Citrobacter and Enterobacter. BMC Microbiol. 2013, 13, 152. [Google Scholar] [CrossRef]
- Jin, P.; Wang, H.; Tan, Z.; Xuan, Z.; Dahar, G.Y.; Li, Q.X.; Miao, W.; Liu, W. Antifungal mechanism of bacillomycin D from Bacillus velezensis HN-2 against Colletotrichum gloeosporioides Penz. Pestic. Biochem. Physiol. 2020, 163, 102–107. [Google Scholar] [CrossRef] [PubMed]
- Chen, K.; Tian, Z.; Luo, Y.; Cheng, Y.; Long, C.A. Antagonistic activity and the mechanism of Bacillus amyloliquefaciens DH-4 against citrus green mold. Phytopathology 2018, 108, 1253–1262. [Google Scholar] [CrossRef] [PubMed]
- Fan, H.; Zhang, Z.; Li, Y.; Zhang, X.; Duan, Y.; Wang, Q.I. Biocontrol of bacterial fruit blotch by Bacillus subtilis 9407 via surfactin-mediated antibacterial activity and colonization. Front. Microbiol. 2017, 8, 1973. [Google Scholar] [CrossRef] [PubMed]
- Zhao, P.F.; Wang, S.Q.; Xu, Z.L.; Liao, M.D. Tobacco-acquired resistance induced by an exopolysaccharide of Paenibacillus kribbensis PS04 against bacterial wilt. Biocontrol Sci. Technol. 2020, 30, 370–383. [Google Scholar] [CrossRef]
- Qiu, J.E.; Zhao, L.; Jiang, S.; Godana, E.A.; Zhang, X.; Zhang, H. Efficacy of Meyerozyma caribbica in the biocontrol of blue mold in kiwifruit and mechanisms involved. Biol. Control 2022, 173, 105000. [Google Scholar] [CrossRef]
- Jiang, C.H.; Yao, X.F.; Mi, D.D.; Li, Z.J.; Yang, B.Y.; Zheng, Y.; Qi, Y.; Guo, J.H. Comparative transcriptome analysis reveals the biocontrol mechanism of Bacillus velezensis F21 against Fusarium wilt on watermelon. Front. Microbiol. 2019, 10, 652. [Google Scholar] [CrossRef]
- Nisa, H.; Kamili, A.N.; Nawchoo, I.A.; Shafi, S.; Shameem, N.; Bandh, S.A. Fungal endophytes as prolific source of phytochemicals and other bioactive natural products: A review. Microb. Pathog. 2015, 82, 50–59. [Google Scholar] [CrossRef]
- Kim, J.W.; Choi, H.G.; Song, J.H.; Kang, K.S.; Shim, S.H. Bioactive secondary metabolites from an endophytic fungus, Phoma sp. PF2 derived from Artemisia princeps Pamp. J. Antibiot. 2019, 72, 174–177. [Google Scholar] [CrossRef]
- Meng, Q.; Jiang, H.; Hao, J.J.J.B.C. Effects of Bacillus velezensis strain BAC03 in promoting plant growth. Biol. Control 2016, 98, 18–26. [Google Scholar] [CrossRef]
- Yu, X.; Ai, C.; Xin, L.; Zhou, G. The siderophore-producing bacterium, Bacillus subtilis CAS15, has a biocontrol effect on Fusarium wilt and promotes the growth of pepper. Eur. J. Soil Biol. 2011, 47, 138–145. [Google Scholar] [CrossRef]
- Tan, T.; Zhu, J.; Shen, A.; Li, J.; Yu, Y.; Zhang, M.; Zhao, M.; Li, Z.; Chen, J.; Gao, C.; et al. Isolation and identification of a Bacillus subtilis HZ-72 exhibiting biocontrol activity against flax seedling blight. Eur. J. Plant Pathol. 2019, 153, 825–836. [Google Scholar] [CrossRef]
- Chen, L.; Shi, H.; Heng, J.; Wang, D.; Bian, K. Antimicrobial, plant growth-promoting and genomic properties of the peanut endophyte Bacillus velezensis LDO2. Microbiol. Res. 2019, 218, 41–48. [Google Scholar] [CrossRef]
- Xie, Z.; Li, M.; Wang, D.; Wang, F.; Shen, H.; Sun, G.; Feng, C.; Wang, X.; Chen, D.; Sun, X. Biocontrol efficacy of Bacillus siamensis LZ88 against brown spot disease of tobacco caused by Alternaria alternata. Biol. Control 2021, 154, 104508. [Google Scholar] [CrossRef]
- Myo, E.M.; Liu, B.; Ma, J.; Shi, L.; Jiang, M.; Zhang, K.; Ge, B. Evaluation of Bacillus velezensis NKG-2 for bio-control activities against fungal diseases and potential plant growth promotion. Biol. Control 2019, 134, 23–31. [Google Scholar] [CrossRef]
- Chang, W.T.; Chen, Y.C.; Jao, C.L. Antifungal activity and enhancement of plant growth by Bacillus cereus grown on shellfish chitin wastes. Bioresour. Technol. 2007, 98, 1224–1230. [Google Scholar] [CrossRef]
- Shanmugaiah, V.; Mathivanan, N.; Balasubramanian, N.; Manoharan, P.T. Optimization of cultural conditions for the production of chitinase by Bacillus heterosporous MML2270 isolated from rice rhizosphere soil. Afr. J. Biotechnol. 2008, 7, 2562–2568. [Google Scholar]
- Ahmed, E.; Holmström, S.J. Siderophores in environmental research: Roles and applications. Microb. Biotechnol. 2014, 7, 196–208. [Google Scholar] [CrossRef]
- Beneduzi, A.; Ambrosini, A.; Passaglia, L.M. Plant growth-promoting rhizobacteria (PGPR): Their potential as antagonists and biocontrol agents. Genet. Mol. Biol. 2012, 35, 1044–1051. [Google Scholar] [CrossRef]
- Feng, Y.; Tian, B.; Xiong, J.; Lin, G.; Cheng, L.; Zhang, T.; Li, X. Exploring IAA biosynthesis and plant growth promotion mechanism for tomato root endophytes with incomplete IAA synthesis pathways. Chem. Biol. Technol. Agric. 2024, 11, 187. [Google Scholar] [CrossRef]
- Moon, J.H.; Won, S.J.; Maung, C.E.H.; Choi, J.H.; Choi, S.I.; Ajuna, H.B.; Ahn, Y.S. Bacillus velezensis CE 100 inhibits root rot diseases (Phytophthora spp.) and promotes growth of Japanese cypress (Chamaecyparis obtusa Endlicher) seedlings. Microorganisms 2021, 9, 821. [Google Scholar] [CrossRef]
- Im, S.M.; Yu, N.H.; Joen, H.W.; Kim, S.O.; Park, H.W.; Park, A.R.; Kim, J.C. Biological control of tomato bacterial wilt by oxydifficidin and difficidin-producing Bacillus methylotrophicus DR-08. Pestic. Biochem. Physiol. 2020, 163, 130–137. [Google Scholar] [CrossRef] [PubMed]
- Wang, H.; Meng, J.; Peng, X.; Tang, X.; Zhou, P.; Xiang, J.; Deng, X. Rice WRKY4 acts as a transcriptional activator mediating defense responses toward Rhizoctonia solani, the causing agent of rice sheath blight. Plant Mol. Biol. 2015, 89, 157–171. [Google Scholar] [CrossRef] [PubMed]
- Peng, X.; Wang, H.; Jang, J.C.; Xiao, T.; He, H.; Jiang, D.; Tang, X. OsWRKY80-OsWRKY4 module as a positive regulatory circuit in rice resistance against Rhizoctonia solani. Rice 2016, 9, 1–14. [Google Scholar] [CrossRef] [PubMed]
- Qiu, Y.; Yan, H.H.; Sun, S.M.; Wang, Y.Q.; Zhao, X.R.; Wang, H.Y. Use of Bacillus velezensis SDTB022 against tobacco black shank (TBS) and the biochemical mechanism involved. Biol. Control 2022, 165, 104785. [Google Scholar] [CrossRef]
- Wang, Y.; Zhang, C.; Liang, J.; Wang, L.; Gao, W.; Jiang, J.; Chang, R. Surfactin and fengycin B extracted from Bacillus pumilus W-7 provide protection against potato late blight via distinct and synergistic mechanisms. Appl. Microbiol. Biotechnol. 2020, 104, 7467–7481. [Google Scholar] [CrossRef]
- Nakata, M.; Shiono, T.; Watanabe, Y.; Satoh, T. Salt stress-induced dissociation from cells of a germin-like protein with Mn-SOD activity and an increase in its mRNA in a moss, Barbula unguiculata. Plant Cell Physiol. 2002, 43, 1568–1574. [Google Scholar] [CrossRef][Green Version]
- Shine, M.B.; Yang, J.W.; El-Habbak, M.; Nagyabhyru, P.; Fu, D.Q.; Navarre, D.; Kachroo, A. Cooperative functioning between phenylalanine ammonia lyase and isochorismate synthase activities contributes to salicylic acid biosynthesis in soybean. New Phytol. 2016, 212, 627–636. [Google Scholar] [CrossRef]
- Richter, H.; Lieberei, R.; Strnad, M.; Novák, O.; Gruz, J.; Rensing, S.A.; von Schwartzenberg, K. Polyphenol oxidases in Physcomitrella: Functional PPO1 knockout modulates cytokinin-dependent development in the moss Physcomitrella patens. J. Exp. Bot. 2012, 63, 5121–5135. [Google Scholar] [CrossRef]
- Singh, R.; Sunder, S.; Kumar, P. Sheath blight of rice: Current status and perspectives. Indian Phytopathol 2016, 69, 340–351. [Google Scholar]
- Wei, Z.M.; Laby, R.J.; Zumoff, C.H.; Bauer, D.W.; He, S.Y.; Collmer, A.; Beer, S.V. Harpin, elicitor of the hypersensitive response produced by the plant pathogen Erwinia amylovora. Science 1992, 257, 85–88. [Google Scholar] [CrossRef]

| Entry Number | |||
|---|---|---|---|
| Specific Name | Strain Name | 16S | gyrA |
| Bacillus amyloliquefaciens | DSM7 | NR_118950.1 | FN597644.1 |
| Bacillus atrophaeus | UCMB-5137 | CP011802.1 | CP011802.1 |
| Bacillus cereus | ATCC 14579 | NR_074540.1 | CP034551.1 |
| Bacillus inaquosorum | LBA001 | NZ_CP127095.1 | NZ_CP127095.1 |
| Bacillus mojavensis | UCMB5075 | CP051464.1 | CP051464.1 |
| Bacillus Nakamura | NRRL B-41091 | LSAZ01000028.1 | LSAZ01000005.1 |
| Bacillus pumilus | 145 | CP027116.1 | CP027116.1 |
| Bacillus pumilus | DSM 27 | CP046130.1 | CP046130.1 |
| Bacillus siamensis | KCTC 13613 | MN176482.1 | AJVF01000039.1 |
| Bacillus sonorensis | PMC204 | NZ_CP139190.1 | NZ_CP139190.1 |
| Bacillus subtilis | BEST3096 | AP024622.1 | AP024622.1 |
| Bacillus subtilis | DSM 5611 | CP120603.1 | CP120603.1 |
| Bacillus tequilensis | EA-CB0015 | NZ_CP048852.1 | NZ_CP048852.1 |
| Bacillus vallismortis | DSM 11031 | NZ_CP026362.1 | NZ_CP026362.1 |
| Bacillus velezensis | B-001 | CP087957.1 | CP087957.1 |
| Bacillus velezensis | DMW1 | NZ_CP114180.1 | NZ_CP114180.1 |
| Escherichia coli | L1 E925 | LR883050.1 | LR883050.1 |
| Strains | |
|---|---|
| Physiological and Biochemical Project | B5 |
| V-P | − |
| Citrate | + |
| Propionate | − |
| D-xylose | + |
| L-arabinose | − |
| D-mannitol | + |
| gelatin liquefaction | + |
| NaCl Salt tolerance test | 0–10% |
| PH growth | 4.5–8.5 |
| Nitrate reduction | + |
| Treatment | Incidence (%) | Disease Index | Relative Efficacy (%) |
|---|---|---|---|
| CK1 | |||
| CK2 | 100.00 ± 0.00 a | 32.92 ± 0.58 a | |
| B5 | 64.81 ± 0.05 b | 12.96 ± 1.01 b | 60.66 ± 0.02 a |
| 10% Tebuconazole WDG | 68.51 ± 0.003 b | 14.20 ± 0.50 b | 54.86 ± 0.03 a |
| Filtrate Concentration | Colony Diameters (mm) | Inhibition Rate (%) |
|---|---|---|
| 5% | 55.38 ± 1.39 | 23% e |
| 10% | 46.98 ± 1.21 | 35% d |
| 15% | 31.86 ± 1.67 | 56% c |
| 20% | 5.88 ± 0.30 | 91% b |
| 25% | 0 | 100% a |
| Material Type | Molecular Formula | Ion Binding Form | Mass/Charge | Retention Time |
|---|---|---|---|---|
| Betaine | C5H11NO2 | [M+H]+ | 118.0863 | 26.46 |
| Uridine | C9H12N2O6 | [M+H]+ | 245.0768 | 9.23 |
| Cyclo(Proline–Leucine) dipeptide | C50H78N12O14 | [M+H]+ | 211.1441 | 4.56 |
| Cyclo(D-Phenylalanine-L-Proline | C53H93N7O13 | [M+H]+ | 245.1285 | 5.10 |
| Iturin A-7 | C31H45O6P | [M+H]+ | 1071.5833 | 7.76 |
| SurfactinC | C12H18N2O5 | [M+H]+ | 1036.6904 | 10.64 |
| Toxenutin | C33H42O19 | [M+H]+ | 743.2393 | 0.89 |
| Bacillaene | C34H48N2O6 | [M+H]+ | 666.3345 | 4.62 |
| Surfactin A | C51H89N7O13 | [M+H]+ | 1008.6591 | 9.96 |
| Surfactin B | C52H89N7O13 | [M+H]+ | 1022.6748 | 10.31 |
| 4′,5-Trimethoxy-trans-stilbene | C17H18O3 | [M+H]+ | 271.1329 | 7.52 |
| Betaine | C5H11NO2 | [M+H]+ | 118.0863 | 26.46 |
Disclaimer/Publisher’s Note: The statements, opinions and data contained in all publications are solely those of the individual author(s) and contributor(s) and not of MDPI and/or the editor(s). MDPI and/or the editor(s) disclaim responsibility for any injury to people or property resulting from any ideas, methods, instructions or products referred to in the content. |
© 2025 by the authors. Licensee MDPI, Basel, Switzerland. This article is an open access article distributed under the terms and conditions of the Creative Commons Attribution (CC BY) license (https://creativecommons.org/licenses/by/4.0/).
Share and Cite
Qin, Q.; Liu, B.; Ma, B.; Wei, X.; Zhou, Y.; Sun, Z. Isolation and Identification of Endophytic Bacterium B5 from Mentha haplocalyx Briq. and Its Biocontrol Mechanisms Against Alternaria alternata-Induced Tobacco Brown Spot. J. Fungi 2025, 11, 446. https://doi.org/10.3390/jof11060446
Qin Q, Liu B, Ma B, Wei X, Zhou Y, Sun Z. Isolation and Identification of Endophytic Bacterium B5 from Mentha haplocalyx Briq. and Its Biocontrol Mechanisms Against Alternaria alternata-Induced Tobacco Brown Spot. Journal of Fungi. 2025; 11(6):446. https://doi.org/10.3390/jof11060446
Chicago/Turabian StyleQin, Qunying, Boyu Liu, Baige Ma, Xihong Wei, Yi Zhou, and Zhengxiang Sun. 2025. "Isolation and Identification of Endophytic Bacterium B5 from Mentha haplocalyx Briq. and Its Biocontrol Mechanisms Against Alternaria alternata-Induced Tobacco Brown Spot" Journal of Fungi 11, no. 6: 446. https://doi.org/10.3390/jof11060446
APA StyleQin, Q., Liu, B., Ma, B., Wei, X., Zhou, Y., & Sun, Z. (2025). Isolation and Identification of Endophytic Bacterium B5 from Mentha haplocalyx Briq. and Its Biocontrol Mechanisms Against Alternaria alternata-Induced Tobacco Brown Spot. Journal of Fungi, 11(6), 446. https://doi.org/10.3390/jof11060446
